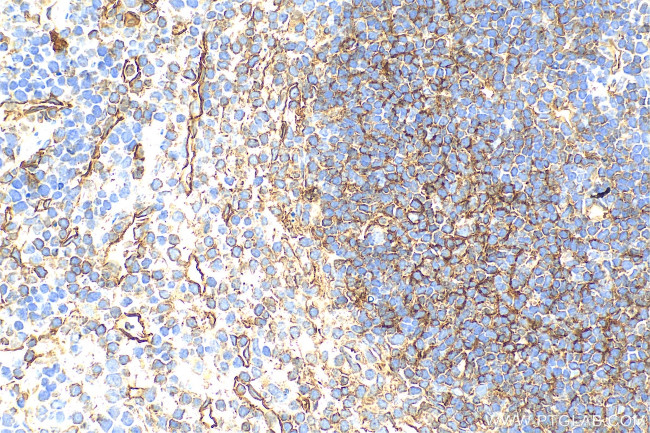
CD200 Antibody in Immunohistochemistry (Paraffin) (IHC (P))

Search
Proteintech
CD200 Polyclonal Antibody
{{$productOrderCtrl.translations['antibody.pdp.commerceCard.promotion.promotions']}}
{{$productOrderCtrl.translations['antibody.pdp.commerceCard.promotion.viewpromo']}}
{{$productOrderCtrl.translations['antibody.pdp.commerceCard.promotion.promocode']}}: {{promo.promoCode}} {{promo.promoTitle}} {{promo.promoDescription}}. {{$productOrderCtrl.translations['antibody.pdp.commerceCard.promotion.learnmore']}}
产品信息
31444-1-AP
种属反应
宿主/亚型
分类
类型
抗原
偶联物
形式
浓度
纯化类型
保存液
内含物
保存条件
运输条件
靶标信息
CD200 is a type-1 membrane glycoprotein in the immunoglobulin superfamily, featuring two immunoglobulin domains. It is widely expressed on various cells, including B and T cells, keratinocytes, nerve cells, follicular dendritic cells, ovarian cells, and trophoblasts. CD200 interacts with CD200R on myeloid cells, inhibiting macrophage activation, reducing IL-6 production, and attenuating lymphocyte activation. It also prevents mast cell degranulation and decreases TNF-alpha and IL-13 secretion, playing a role in immune regulation and maternal tolerance. Homologues of CD200 are found in herpesviruses and poxviruses, indicating a conserved immune modulation function. CD200 has multiple alternatively spliced transcript variants, contributing to its functional diversity. Diseases linked to CD200 dysfunction include Mantle Cell Lymphoma and Primary Hypertrophic Osteoarthropathy, highlighting its importance in health and disease.
仅用于科研。不用于诊断过程。未经明确授权不得转售。
篇参考文献 (0)
生物信息学
蛋白别名: antigen identified by monoclonal antibody MRC OX-2; Cd200 antigen; cell surface protein (thymocyte antigen identified by monoclonal antibody MRC-OX2); MRC OX-2 antigen; OX-2 membrane glycoprotein
基因别名: Cspmo2; Mox2; MRCOX2; OX2
Entrez Gene ID: (Mouse) 17470, (Rat) 24560